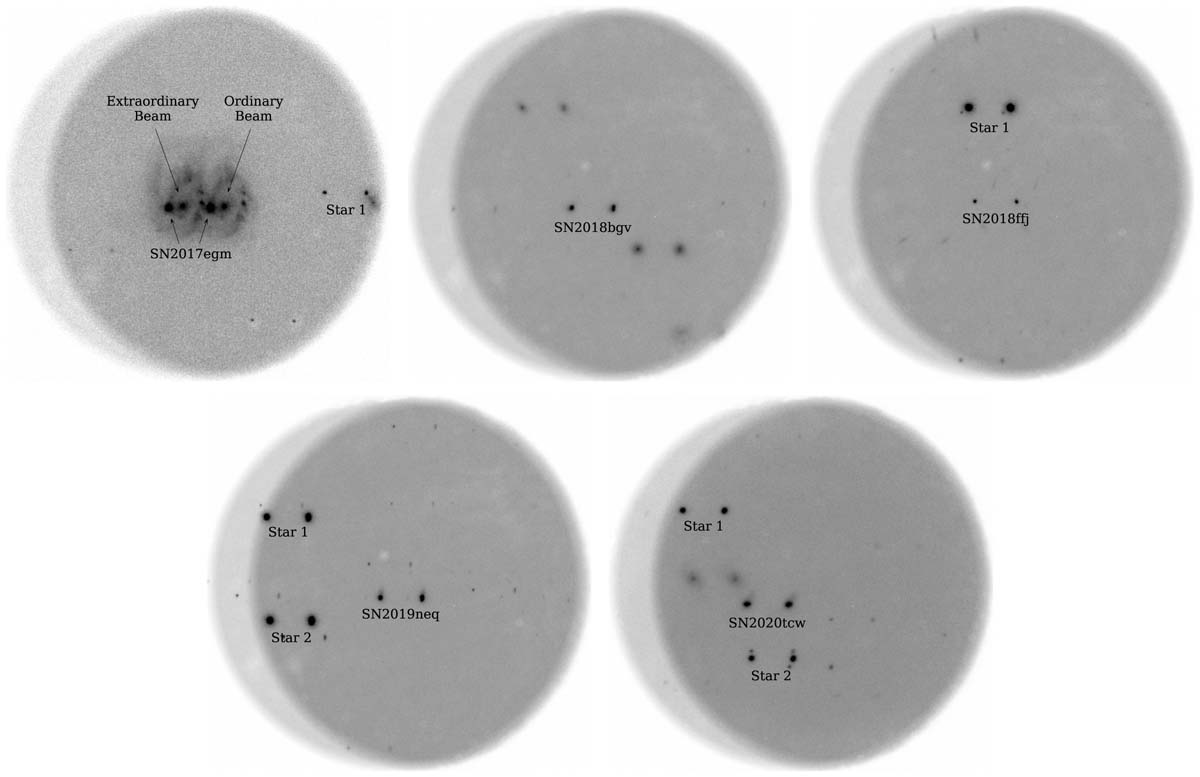
image

Fig. C.1.
Download original image
Example NOT/ALFOSC polarimetry images for SN 2017egm, SN 2018bgv, SN 2018ffj, SN 2019neq and SN 2020tcw. In the polarimetric mode, the e (left) and o beams (right) are overlaid with an offset of 15″. In addition to the SNe, bright point sources (i.e. stars) have been marked in the images. For SN 2017egm, Star 1 is located on the edge of the e beam image and is unreliable to estimate the ISP. No stars are present in the FOV of SN 2018bgv. Star 1 was used to estimate the ISP for SN 2018ffj. For SN 2019neq, only Star 2 is used to determine the ISP as Star 1 is found on the edge of the o beam image resulting in an unreliable ISP estimate. Only Star 1 is used to estimate the ISP of SN 2020tcw as Star 2 has several objects in the close vicinity and the ISP cannot be reliably identified.
Current usage metrics show cumulative count of Article Views (full-text article views including HTML views, PDF and ePub downloads, according to the available data) and Abstracts Views on Vision4Press platform.
Data correspond to usage on the plateform after 2015. The current usage metrics is available 48-96 hours after online publication and is updated daily on week days.
Initial download of the metrics may take a while.


